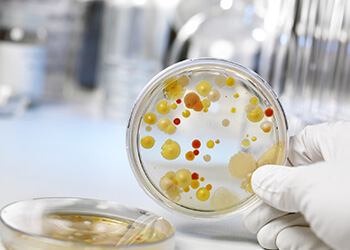
Симптомы Уреаплазмозы у женщин Симптомы Уреаплазмозы

Такое заболевание, как уреаплазмоз, провоцирует патогенный микроорганизм, который сочетает в своей форме и признаки вируса, и строение одноклеточного организма. То есть, попадая в организм, эта патогенная флора является транзитным транспортом для вирусной инфекции, которая путешествует на нем.
Уреаплазмоз у женщин вызывает многие заболевания в мочеполовой системе, которые могут быть воспалительными, а также перетекать в хроническую форму. Для женщин проникновение уреплазмоза внутрь губительно еще и тем, что оно может привести к бесплодию, либо в будущем сыграть роль в развитии различных патологий у плода.
Особенности протекания уреаплазмоза у женщин
Стартовое развитие этой патологии проходит либо безо всяких симптомов, либо они настолько незначительны, что женщина практически не отличает их от своих обычных ощущений. Поэтому заметить присутствие патологии совсем непросто. И женщинам, а особенно перед тем, как планировать беременность, просто необходимо пройти обследование и сдать анализы на предмет скрытых инфекций, чтобы избежать возникновения внезапного самопроизвольного прерывания беременности при уреаплазмозе или наличия аномальных изменений у ребенка.
Особенности протекания инкубационного периода также имеют сильно размытые границы, потому что с момента инфицирования до момента развития уреаплазмоза может пройти от 20 дней до нескольких лет, к тому же заболевание может протекать в скрытой форме, проявляя себя только при общем спаде самочувствия. Да и то, если учитывать индивидуальные особенности, то некоторые женщины могут быть просто носителями патогена и передавать его дальше.
Урологи утверждают, что уреаплазмоз считается выявленным, если в биологических анализах пациента обнаруживается патогенная флора, которая может быть характерна для этого вида заболевания. Но если есть какие-либо примеси, которые говорят о том, что наличествует еще какая-то патогенная бактериальная база, тогда проводятся дополнительные исследования с целью выяснения профилирующего заболевания, угнетающего нормальное функционирование мочеполовой системы у женщины.
К особенностям, которые сопровождают течение уреалазмоза у женщин, также относится и то, что инкубационный период имеет затянутый характер, к тому же болезнь может проходить довольно вяло и обостриться только на фоне другого воспалительного процесса.
Для женщин характерны следующие симптомы уреаплазмоза:
- при мочеиспускании появляется сильный зуд в уретре;
- появляются обильные выделения белого цвета;
- моча может быть мутная с оранжевым оттенком.
Если при первых симптомах уреаплазмоза у женщины она не обращается за медицинской помощью, тогда недуг будет развиваться. Даже если симптомы уреаплазмоза у женщины прошли, если не применялось лечение, то это всего лишь означает, что болезнь на время угасла и вскоре снова заявит о себе. Такое затихание инфекционного процесса может происходить вследствие того, что укрепилась иммунная система или поменялись условия жизни, и организм немного освободился от ежедневной нагрузки.
Но, как только снова произойдет падение общего уровня самочувствия, то патогенная микрофлора сразу же станет активной и нанесет новый удар; а еще уреаплазамоз дает благотворную почву для того, чтобы попавшие в организм возбудители других заболеваний, и в том числе венерических, могли сразу же комфортно обосноваться.
Врачи отмечают, что уреаплазмоз у женщин может возникать по нескольким причинам. Одной из основных является нарушение микрофлоры влагалища, что может произойти из-за частых смен половых партнеров, незащищенных половых актов и использования антибиотиков. Также врачи подчеркивают, что стресс и ослабление иммунной системы играют значительную роль в развитии инфекции. Хронические заболевания, такие как диабет или заболевания щитовидной железы, могут способствовать активизации уреаплазм. Кроме того, недостаточная гигиена и несоблюдение правил личной гигиены также могут привести к заражению. Важно, чтобы женщины обращались к специалистам при первых симптомах, чтобы избежать осложнений и своевременно получить необходимое лечение.
https://youtube.com/watch?v=SqP61fDG8z8
Симптоматика уреаплазмоза
В небольших количествах микроорганизмы уреаплазмы постоянно присутствуют на слизистой оболочке, но процесс обострения начинается только при стечении определенных обстоятельств.
Симптомы, которые характеризуют уреалазмоз у женщины, следующие:
- выделения обильные из влагалища – по большей части они мутно-белого цвета, но без какого-либо постороннего запаха. Но если цвет выделений меняется на желтый и появляется резкий запах, то это значит, что в мочеполовой системе началось какое-то воспаление;
- тянущие или резкие боли в области матки и придатков могут говорить о том, что уреалазмоз спровоцировал какой-либо процесс воспаления в придатках или в матке женщины;
- постоянная потребность в опорожнении мочевого пузыря – это самый частый симптом, который свидетельствует о наличии уреалазмоза, но такой же симптом сопровождает и цистит. Болезненные ощущения в мочевом канале тоже предвестники заболевания, а также жжение и зуд;
- болезненные ощущения и сильный дискомфорт в районе влагалища во время совершения акта соития либо уже по прошествии его.
Если дамы бережно относятся к своему здоровью, то необходимо один раз в полгода сдавать посев на присутствие патогенной флоры. И, при обнаружении таковой, надо обязательно пройти курс лечения.
Причины заражения
Заражение уреаплазмозом возможно, в большинстве случаев, если у женщины была близость с носителем вируса, и половой контакт при этом не был защищен. Но для того, чтобы сразу подхватить болезнь, у женщины должны проходить какие-то воспалительные или инфекционные процессы, которые отвлекают большую часть внимания иммунной системы на себя.
Следующие условия создают наиболее комфортную для проникновения бактерии почву:
- ослабление всех систем, в том числе иммунной и функциональной;
- большой транзитный фон пробирающихся микроорганизмов, несущих на себе вирусное заболевание;
- иссушение или воспаление эпителия, слизистый слой которого должен защищать мочеполовую систему;
- хронические или генетические заболевания, которые присутствуют в организме.
Причины, которые могут послужить тому, что женщина заразится урепалазмзом:
- самый вероятный и наиболее распространённый – это через сексуальный контакт с носителем. Особенно часто это бывает, когда женщина не разборчива в связях;
- есть возможность заражения девочки еще при родах, когда у матери уже инфицированы половые органы, и вирусы поражают плод, когда тот проходит по родовым путям;
- самый минимальный риск, но он все равно существует, – это когда женщина заражается контактным способом, через бытовые предметы;
- также вспышка уреаплазмоза может произойти из-за того, что пациентка принимает слишком большое количество препаратов антибактериального характера, причем неконтролируемо, без назначения специалиста;
- типично возникновение рассматриваемого вируса в тот момент, когда происходит гормональная терапия, которая должна скорректировать какое-либо заболевание, но при этом может вызвать и признаки уреаплазмоза у женщины;
- ежедневное стрессовое состояние тоже угнетает работоспособность организма и может привести к активации микробов;
- если у женщины, в силу каких-то причин, изменились условия проживания и это отражается на ее психоэмоциональном фоне – это тоже причина развития заболевания.
То есть стоит помнить о том, что, кроме основного процесса, который напрямую приводит к инфицированию, существуют еще и дополнительные обстоятельства, которые могут повлиять на то, что женщина заболеет.
Уреаплазмоз — это инфекционное заболевание, которое вызывает микроорганизм Ureaplasma urealyticum. Многие женщины задаются вопросом о причинах его возникновения. Одной из основных причин считается незащищённый половой акт, так как инфекция передаётся половым путём. Кроме того, ослабленный иммунитет, стресс и гормональные изменения могут способствовать активизации уреаплазмы, которая может находиться в организме в латентной форме. Некоторые женщины отмечают, что частые смены партнёров и недостаточная гигиена также играют роль в развитии инфекции. Важно помнить, что уреаплазмоз может протекать бессимптомно, поэтому регулярные медицинские обследования и внимательное отношение к своему здоровью помогут выявить проблему на ранних стадиях.
https://youtube.com/watch?v=Zk3eDmG_-Hk
Какие осложнения могут возникать побочно у женщин при уреаплазмозе
Урологи проводили и проводят довольно много клинических испытаний и лабораторных тестов для того, чтобы понимать, какие осложнения могут возникнуть у женщины, если в организме хозяйничает уреаплазмоз. Итоги таких исследований говорят о том, что:
- основная опасность таится в том, что микроорганизмы, которые являются носителями вируса, могут почти полностью подавить репродуктивную способность женщины. Она не сможет ни забеременеть, ни выносить ребенка. Тем более, даже при успешной беременности, у развивающегося плода могут быть патологии или они возникнут у рожденного младенца;
- также инфицируется и камера мочевого пузыря, и сразу же подхватываются другие, не менее опасные, заболевания;
- открывается путь к приобретению заболеваний типа пиелонефрита.
Профилактика возникновения уреаплазмоза у женщин
Основным в профилактике такого сложного в излечении заболевания является то, что женщина должна посещать гинеколога на предмет профилактического осмотра.
А также необходима постоянная интимная гигиена, умеренное употребление недостающих витаминов и организация своего ритма жизни таким образом, чтобы стрессовых ситуаций было как можно меньше.
Современная практика клинических урологов говорит о том, что несерьезное отношение к такому опасному заболеванию может не только серьезно повредить здоровье женщин и в принципе сказаться на демографическом фоне, но и создать ситуацию, когда инфекция расходится от одного зараженного к другому.
Лечение уреаплазмоза
Лечением уреаплазмоза у женщин должен заниматься специалист, потому что самолечение может привести к тому, что еще больше ослабнет иммунная система и пострадают внутренние органы. Тем более одномоментно, для успешного результата, надо лечить обоих половых партнеров, потому что в обратном случае заражение будет повторяться.
Лечебный курс предполагает, что назначается цикл процедур и прием медикаментов, которые должны купировать заболевание. Обычно назначаются препараты следующего действия:
- антибактериальные медикаментозные препараты;
- антимикробные лекарства;
- иммуностимуляторы для поднятия общего тонуса.
Сам терапевтический курс занимает около двух недель, а затем необходимо сдать новый посевной мазок, чтобы убедиться в том, что результат достигнут, заболевание не прогрессирует и купировано.
Также доктор может назначить дополнительные физиотерапевтические процедуры.
https://youtube.com/watch?v=6mX_NNSFCMY
Вопрос-ответ
Можно ли полностью вылечить уреаплазму у женщин?
Полностью вылечить болезнь нельзя.
Как долго уреаплазма может жить в организме?
Заражение уреаплазмозом, как правило, происходит при половом контакте, а также внутриутробно и во время родов от матери к ребенку. Если уреаплазма попадает в родовые пути к ребенку, то может жить в организме довольно много лет без каких-либо проявлений и симптомов.
Откуда у мужа уреаплазма?
Передача возбудителя нозологии у мужчин происходит половым путем. Основные факторы риска: раннее начало половой жизни, большое число сексуальных партнеров, неиспользование барьерных средств контрацепции, симптомы хронических воспалительных процессов мочеполового аппарата.
Советы
СОВЕТ №1
Регулярно проходите медицинские обследования. Уреаплазмоз может протекать бессимптомно, поэтому важно регулярно посещать гинеколога и сдавать анализы на инфекции, передающиеся половым путем.
СОВЕТ №2
Обратите внимание на личную гигиену. Соблюдение правил личной гигиены, таких как регулярная смена нижнего белья и использование средств для интимной гигиены, может помочь снизить риск возникновения инфекций, включая уреаплазмоз.
СОВЕТ №3
Избегайте незащищенных половых контактов. Использование презервативов не только защищает от беременности, но и снижает риск передачи инфекций, включая уреаплазму. Это особенно важно при смене половых партнеров.
СОВЕТ №4
Укрепляйте иммунную систему. Здоровый образ жизни, включая правильное питание, физическую активность и достаточный сон, поможет укрепить иммунитет и снизить вероятность развития инфекций.